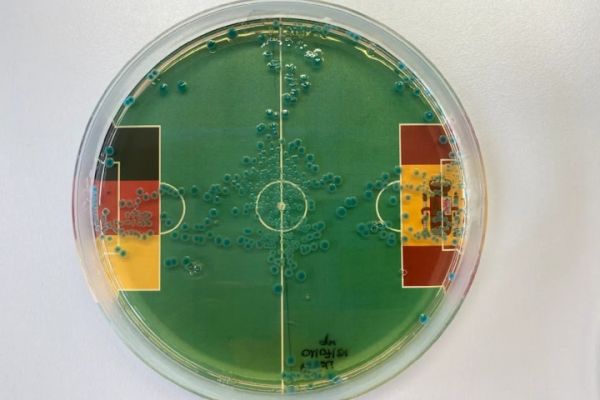
پیشگویی باکتری‌ها از نتیجه بازی آلمان و اسپانیا چیست

پایگاه خبری فوتبالی - پس از آن که یک هشت پا نتایج جام جهانی 2010 را به درستی پیشگویی کرد، در سالهای اخیر بسیاری از حیوانات سعی کردند که نتایج را پیش بینی کنند، از زرافه گرفته تا خرس، فیل، شتر و حالا یک موجود زنده و عجیب دیگر به سراغ پیشگویی رفته است!
به گزارش فوتبالی، جدیدترین پیشگوی مسابقات فوتبال، باکتری ها هستند. در حقیقت یک میکروبیولوژیست به نام مارکوس اگرت تصمیم گرفته که از باکتری ها برای پیش بینی نتایج یورو استفاده کند. اگرت معتقد است که باکتری ها می توانند به موفقیتی جدید در حوزه پیش بینی فوتبال تبدیل شوند.
دکتر اگرت توانسته چند گرم باکتری را برای پیش بینی بازیهای فوتبال پرورش بدهد. او این باکتری ها را در یک ظرف قرار داده و برای هر بازی، پرچم هر کشور را در آن ظرف قرار می دهد. او این باکتری ها را در ظرف پخش می کند تا بفهمد که کدام تیم بیشتر گل می زند. این باکتری ها پیشگویی کرده اند که آلمان قهرمان یورو می شود و انگلیس و فرانسه مدعیان بعدی هستند.
حالا برای بازی اسپانیا و آلمان نیز پیشگویی از جانب باکتری های دکتر مارکوس اگرت انجام شده است. این باکتری ها تا کنون نتایج بازیهای آلمان را به درستی پیش بینی کرده اند. البته پیش بینی آنها این بود که آلمان در وقت اضافه مقابل دانمارک پیروز می شود اما آنها در جریان بازی پیروز شدند. باکتری ها حالا پیشگویی کرده اند که آلمان مقابل لاروخا پیروز می شود و به راحتی بر اسپانیا غلبه می کند و به نیمه نهایی یورو راه پیدا می کند.
4125